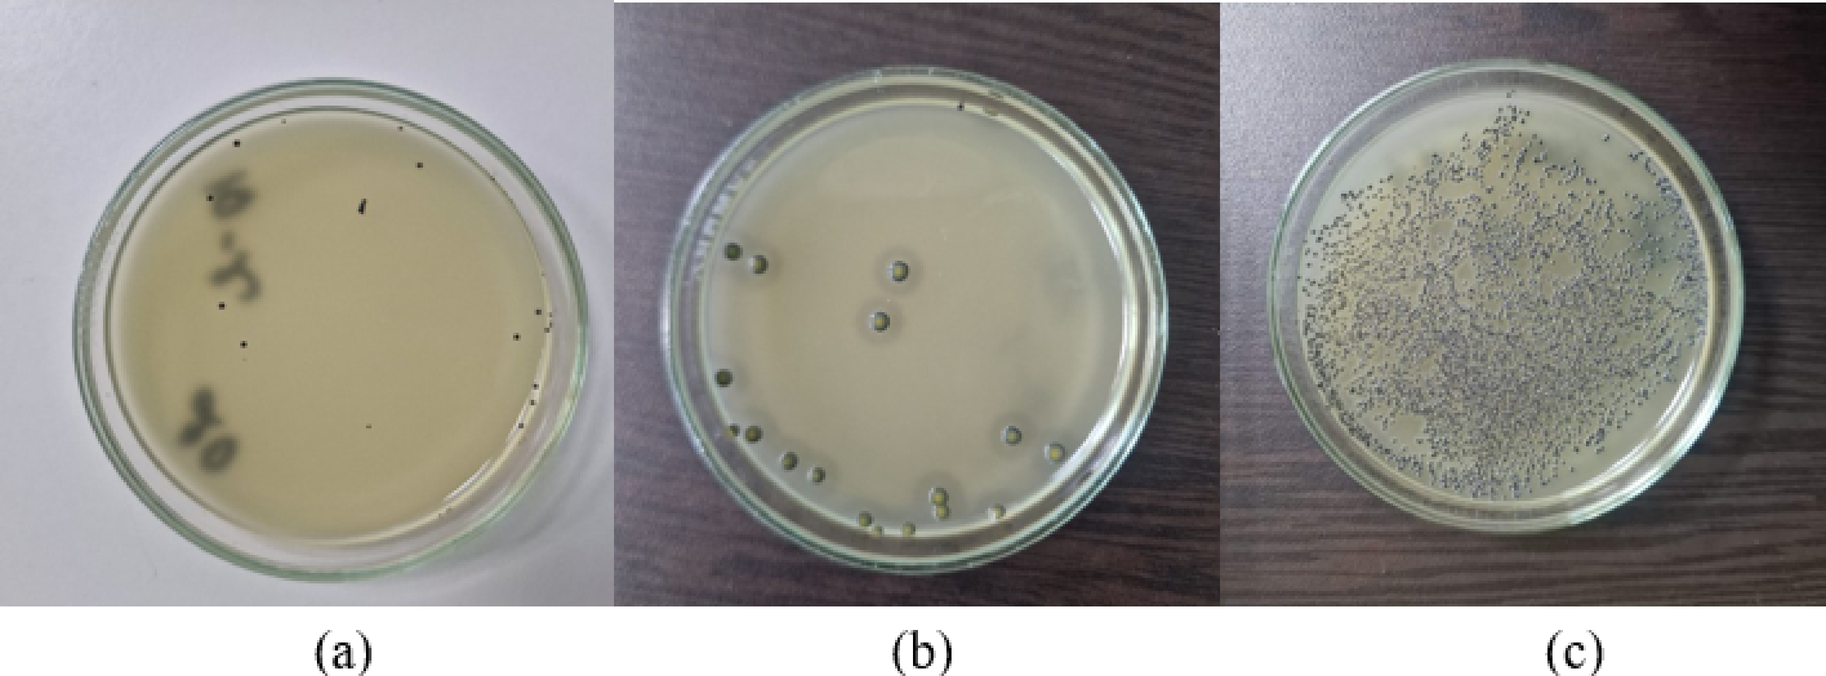
Fig. 4

Fig. 4
Typical colonies of coagulase-positive staphylococci on Baird-Parker agar after inoculation of Staphylococcus aureus ATCC 29213 in cheese and brine. Images (a) and (b) show brine containing OEO. The results illustrate the ineffective inhibitory potential of OEO at a concentration of 0.12% (v/v). (a) Inoculation assessed after 24 h of cultivation, with no visible opalescent halo around the black colonies. (b) Colonies observed after 48 h of cultivation, showing a well-defined and visible opalescent halo surrounding the microbial colonies. (c) Microbial growth after 24 h of cultivation in the positive control sample, which does not contain OEO. All inoculations in (a), (b), and (c) were plated from a 10⁻1 dilution.